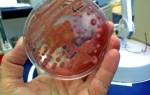

Клебсиелла в моче: причины klebsiella pneumoniae у взрослых

Клебсиелла в моче часто становится тревожным признаком серьезных патологий. Само ее присутствие в организме еще не говорит о развитии болезни, но вероятность ее развития в определенных условиях достаточно велика.
В связи с тем, что наличие такой инфекции не предвещает ничего хорошего, с ней необходимо бороться, не дожидаясь тяжелых последствий.
Современные средства позволяют обеспечить эффективное лечение, но важно его начать своевременно.
Сущность проблемы
Бактерия клебсиелла относится к микроорганизмам с условной патогенностью.
Другими словами, она очень часто присутствует в человеческом организме, ничем себя не проявляя, но способна начать свою патологическую миссию при появлении благоприятных условий, в частности при снижении иммунной защищенности.
Эта инфекция является грамотрицательным микроорганизмом из разряда энтеробактерий. Она обладает достаточно прочной наружной капсулой, которая обеспечивает ее высокую выживаемость в окружающей среде, в т. ч. при повышенной температуре и воздействии многих антибиотиков.
Один из самых распространенных вариантов выявления этой заразы в человеческом организме — клебсиелла пневмония (klebsiella pneumoniae в моче) указывает на присутствии такой разновидности бактерии в мочевыделительной системе (почках, мочевом пузыре, мочеточнике или мочевыводящем канале). Нередко в моче можно выявить еще один тип бактерии — клебсиелла окситока. Надо отметить, что инфекция поражает людей обоих полов, причем фиксируется как у взрослых, так и у детей разного возраста.
Наличие такого микроорганизма, как клебсиелла пневмония в моче, в принципе, нельзя расценивать как патологию. Она очень часто входит в состав естественной микрофлоры мочевыводящей системы.
Установлено, что физиологическая норма присутствия таких видов, как пневмония и окситока, в моче достигает 90000–105000 колониеобразующих единиц (КОЕ) на 1 мл.
Повышение этого уровня указывает на развитие урологических проблем, а значит, требуется лечение.
Этиология явления
Основные причины инфекции: человек-носитель бактерий и собственные микроорганизмы, находящиеся в латентном состоянии.
Заражение чаще всего происходит при нарушении элементарных гигиенических правил: через загрязненные руки, немытые плоды, зараженные продукты (молочные и мясные изделия).
Инфицирование может происходить и воздушно-капельным путем при близком общении с зараженным человеком (кашель, чихание).
Хорошо работающая иммунная система способна противостоять бактериям. Активизируется клебсиеллезная инфекция при сбоях в работе иммунитета. Данное явление могут провоцировать такие причины:
- вредные привычки, особенно чрезмерное потребление алкоголя;
- частое перенесение простудных заболеваний и гриппа;
- онкологические проблемы;
- сахарный диабет;
- нарушение процесса кроветворения;
- трансплантация органов;
- продолжительный курс сильнодействующих антибиотиков;
- патологии, связанные с иммунодефицитом;
- урологические патологии.
Немаловажную роль играет возрастной фактор: часто подвержены заболеванию младенцы с неокрепшим иммунитетом и пожилые люди с возрастным его ослаблением.
Симптоматика активизации бактерий
Оккупировав человеческий организм, клебсиелла выделяет агрессивный эндотоксин — липополисахарид, возникающий при разрушении капсулы бактерии.
При достаточной концентрации его провоцируется реакция инфекционно-токсического типа, характеризующаяся общей интоксикацией организма.
Кроме того, выделяется термостабильный энтеротоксин, ведущий к нарушению системы пищеварения, и мембранотоксин, проявляющий гомолитические способности и разрушающий клеточные ткани.
Если клебсиеллу обнаружили в анализе моче, то, прежде всего, можно предположить развитие патологий мочевыделительной системы: пиелонефрит, цистит, уретрит, кольпит. Инфекция вызывает достаточно активный воспалительный процесс с такими проявлениями, как жжение и болезненность при мочеиспускании, болевой синдром в области поясницы.
Помимо прямого поражения мочеполовой системы, токсины распространяются по всему организму, вызывая нарушения в различных внутренних органах. Одним из самых опасных проявлений считается особый тип пневмонии, провоцируемый klebsiella pheumonial.
Она встречается достаточно редко, но развивается стремительно и может привести к трагическим последствиям.
Чаще возбуждается легочная воспалительная реакция, выражающаяся такими симптомами, как одышка, кашель с мокротой и неприятным запахом, повышенное потоотделение, подъем температуры тела, озноб, признаки общей интоксикации организма.
Попадая в ЖКТ, клебсиелла способна вызвать серьезные нарушения воспалительного характера. Воспаление желудочной слизистой оболочки (гастрит) характеризуется болевым синдромом в районе желудка, тошнотой и рвотой, изжогой, ухудшением аппетита и похудением.
При поражении кишечника может провоцироваться энтерит или энтероколит острого типа. В этом случае выявлена такая симптоматика: болевые схваткообразные приступы в области живота, диарея с кровяными примесями, тошнота, общая слабость.
Острые проявления могут отмечаться в течение 3–4 суток.
Тяжелое течение инфекционного поражения способно привести к сепсису при сильно ослабленном организме, что особенно опасно в детском возрасте. Эндотоксины могут стать причиной токсического шока, а также поражения сосудов. В процесс сепсиса могут вовлекаться самые разные органы: печень, легкие, почки, головной мозг.
В младенческом возрасте наиболее выраженными симптомами клебсиеллозного поражения считаются признаки, напоминающие проявление дисбактериоза, а именно колики, нестабильность стула, учащенное срыгивание, метеоризм. Наиболее характерно появление длительной диареи, что угрожает обезвоживанием детского организма.
Достаточно часто малышей приходится лечить в реанимационном отделении, устраняя общую интоксикацию. В особо тяжелых случаях бактерии могут вызвать геморрагический синдром, легочный отек, токсический шок. В результате наличия в организме ребенка клебсиеллы формируется нестойкая иммунная система.
При таком условии очень вероятны рецидивы инфицирования.
Диагностические мероприятия
Поставить предварительный диагноз клебсиеллозной инфекции очень сложно, в связи с тем что проявляются симптомы, характерные для пораженных органов, а конкретный тип возбудителя может быть выявлен только по результатам лабораторных и инструментальных исследований. В качестве материала используется анализ мочи, крови, мокроты, слизи и т. д.
Для постановки точного диагноза используются следующие диагностические методы:
- Бактериоскопия. Основана на микроскопировании образцов, когда выявляются бактериальные палочки. Определяется вариант их группирования: единичные бактерии, пары или цепочки.
- Бактериологиеский способ. Считается основной методикой диагностики. Он реализуется в виде посева анализа на питательную среду для оценки роста бактериальных колоний. Уже через 20–25 часов обнаруживаются соответствующие колонии, имеющие голубовато-металлический или желтовато-зеленоватый оттенок.
- Серологический способ. Применяется достаточно редко в качестве уточняющего исследования. Такому методу обычно подвергается кровь больного человека для выявления роста титра антител.
- В качестве дополнительных методов применяются инструментальные технологии для уточнения течения осложнений и степени поражения соответствующего органа.
Принципы лечения
Лечение клебсиеллозной инфекции осуществляется с учетом клинической картины, возрастного фактора, особенностей организма, индивидуальной реакции организма на медикаментозные препараты. Терапия может производиться в домашних условиях или путем госпитализации. Последний вариант рекомендуется для маленьких детей и при тяжелом течении патологии.
Лечение обеспечивается по комплексной схеме с назначением таких групп препаратов:
- Антибиотики. С их помощью обеспечивается базовое лечение, т. е. прямое воздействие на возбудителей инфекции. Наиболее часто назначаются тетрациклины, цефалоспорины (третьего и четвертого поколения), аминогликозиды (последнего поколения), пенициллины полусинтетического типа. Иногда используются препараты группы фторхинолонов. Антибиотики подбираются с учетом индивидуальной восприимчивости. Для повышения эффективности данных средств могут составляться комбинации из них.
- Бактериофаги. Такие препараты готовятся на основе вирусных частиц, способных блокировать активность рассматриваемых микроорганизмов и замедлить развитие колоний. Как правило, они принимаются внутрь в форме раствора. Находят применение такие средства, как Бактериофаг клебсиелл пневмонии, Пиобактериофаг поливалентный очищенный жидкий, Бактериофаг клебсиелл поливалентный. Наибольшей популярностью пользуются препараты Экофлор, Энтерол, Бифидум, Трилакт.
- Пробиотики. Такие средства необходимы для восстановления микрофлоры, нарушенной приемом антибиотиков. В зависимости от типа основной терапии выбор делается из таких препаратов: Бифидумбактерин, Пробифор, Аципол, Ацилакт, Бифиформ, Линнекс, Биовестин, Бифилонг, Нормофлорин, Примадофилюкс.
Дополнительное лечение подразумевает симптоматическую терапию, в частности, нередко приходится использовать такие виды, как:
- этиотропная терапия с применением антибактериальных средств;
- патогенетическая терапия для устранения осложнений;
- посиндромальная терапия.
Народные средства
Любое лечение патологий кишечника следует согласовывать со специалистом, при этом народные средства должны использоваться лишь как дополнение к основной комплексной терапии. Необходимо включить в рацион яблочный и клюквенный соки.
К тому же, могут помочь отвары из тысячелистника, осиновой коры, сосновых/березовых почек. Рецепт несложный: 1 ст. л. сухой смеси заливается 1 стаканом кипятка. Средству нужно дать настояться несколько часов, затем разделить на 3 части и выпить за день.
Не нужно забывать о том, что нормализация микрофлоры невозможна, если кишечник забит патогенными микроорганизмами. По этой причине перед тем, как принимать пробиотики, нужно «очиститься» травяными настоями, имеющими фитонцидный эффект. Для этих целей подойдут подорожник или ромашка. Именно эти травы обладают фитонцидным действием. Употреблять отвары следует натощак.
К сожалению, медицина не имеет вакцины, способной победить клебсиеллу. В качестве профилактики можно рекомендовать:
- укрепление иммунитета;
- соблюдение элементарных норм гигиены;
- своевременное лечение инфекций и хронических болезней.
Клебсиелла, обнаруженная в моче, причем в количествах, превышающих норму, свидетельствует о наличии патологического инфекционного развития. Бактерия обладает высокой устойчивостью, но при правильном выборе лечебной схемы можно успешно бороться с болезнью, предотвращая рецидивы.
(6 4,50 из 5) Загрузка…
Клебсиелла пневмония в уретре у мужчин — признаки и лечение, причины и диагностика, способы, средства

Что такое клебсиелла?
Клебсиелла – условно-патогенная бактерия. Присутствует в микрофлоре здорового человека, однако при малом количестве клебсиеллы не вызывают инфекции.
Клебсиелла — неподвижный микроорганизм, может выживать без воздуха. Спор не образуют, но имеют способность создавать вокруг себя капсулу – непроницаемую оболочку, которая защищает бактерию практически от любого внешнего воздействия. Именно поэтому клебсиелла обладает высокой выживаемостью в любых условиях:
- в грунте,
- воде,
- на поверхностях предметов.
Заразиться клебсиеллой легко, уничтожить – не так просто. Погибают эти бактерии только при кипячении в течении 20-30 минут.
Есть минимум 7 разновидностей бактерии, которые живут в разных частях тела, но самой распространенной является клебсиелла пневмонии. При этом воспаление легких она вызывает достаточно редко, поскольку основное место ее обитания – желудочно-кишечный тракт. Если под влиянием различных причин клебсиеллы пневмонии начинают активно размножаться, и у человека развивается клебсиеллез.
Также инфекция может развиться при попадании бактерий на слизистую оболочку мочеполовой системы, дыхательных путей или на поверхность раны.
Биологические свойства
Во время исследований было выявлено, что бактерия легко окрашивается анилиновыми красителями. Она имеет небольшой размер, внешне напоминает коккобациллу. Микроорганизм может существовать в одиночестве, но чаще несколько сотен бактерий обнаруживаются в одном месте.
Бактерия неподвижна и не образует спор, но способна формировать капсулу. При помещении клебсиеллы на питательную среду из агар-агара отмечается образование колоний округлой формы и сероватого цвета. Они слизистые и небольшие. При попадании в среды с содержанием лактозы отмечается их сбраживание, которое обеспечивает именно палочка Фридлендера.
Чем опасна бактерия?
Клебсиеллез – инфекционная болезнь, которая характеризуется поражением ЖКТ, протекает чаще в виде острого гастроэнтерита или воспаления других органов, может даже вызвать сепсис.
Бактерии рода Клебсиелла не только вызывают тяжелые расстройства здоровья, но и имеют способность развивать устойчивость к антибиотикам (резистентность). Поэтому лечение клебсиеллеза – сложный и длительный процесс.
Группа риска по клебсиеллезу
Как уже говорилось, небольшое количество клебсиелл организм здорового человека в состоянии контролировать сам. Клебсиеллез же развивается чаще всего на фоне ослабленного иммунитета.
В группе риска:
- грудные дети;
- пожилые люди;
- пациенты с иммунными проблемами;
- люди, принимающие антибиотики широкого спектра действий.
- пациенты с заболеваниями ЖКТ;
- аллергики;
- имеющие хронические инфекции дыхательной системы;
- больные, принимающие лекарства, угнетающие иммунную систему (например, при лечении аутоиммунных заболеваний).
В пределах этой группы клебсиеллез чаще всего диагностируется у детей до года, поскольку их иммунная система несовершенна и при малейших сложностях не способна дать отпор активному размножению клебсиелл.
Впрочем, если в анализе кала новорожденного малыша обнаружили клебсиеллу, паниковать не стоит.
ВАЖНО! Как уже говорилось, клебсиелла – условно-патогенная бактерия, то есть она может стать причиной патологии только при определенных обстоятельствах. Поэтому полностью списывать на клебсиеллу колики, проблемы со стулом, вздутие живота точно не стоит.
4 самые распространенные детские инфекции и их симптомы
Клебсиолла в период новорожденности
Течение заболевания у детей особенно тяжелое. Часто выявляют возбудителя в моче. Необходимо трехкратное исследование и выяснение причин обнаружения в моче этих микроорганизмов.
У новорожденных детей данная инфекция встречается довольно часто. Проявляется дисбактериоз, который возникает, когда бактерия чрезмерно размножается в кишечных отделах ЖКТ малыша. Если у новорожденных выявляются симптомы диспепсии, то необходим анализ испражнений. Согласно этим исследованиям назначается лечение.
Клебсиеллез у беременных
Может ли ребенок внутриутробно заразиться от матери? Да, это возможно. Заражению малыша всегда предшествуют какие-либо экстрагенитальные инфекции или скрытые ее очаги, генитальные заболевания у матери.
- Инфицирование плода возможно через кровь или плаценту.
- Также заразиться ребенок от матери может восходящим путем: гениталии – влагалище – цервикальный канал – околоплодная оболочка – плод.
- Инфицирование может произойти также через околоплодные воды, когда инфекция проникает в организм неродившегося малыша через слизистые, пупочный канатик, ЖКТ, уши или глаза.
- Контактное инфицирование ребенка возникает во время процесса родов, когда он проходит через родовые пути.
Внутриутробное инфицирование клебсиеллой пороков развития плода не вызывает, но у ребенка может развиться сепсис, пневмония, отит, омфалит, конъюнктивит.
При клебсиеллезе у беременных регистрируется высокий уровень невынашивания беременности и мертворождаемости.
К группе риска по клебсиеллезу относят беременных, имеющих:
- маловодие или многоводие;
- плацентарную недостаточность;
- хориоамнионит;
- синдром задержки развития плода;
- преждевременное излитие околоплодных вод;
- бактериальный вагинит.
Также в группу риска включают беременных, в анамнезе которых:
- искусственное прерывание беременности;
- бесплодие;
- привычное невынашивание;
- преждевременные роды.
Итоги
Клебсиелла – бактерия условно-патогенной части микробиоты кишечника. При полноценной работе иммунной системы болезнетворный микроорганизм находится в мизерной концентрации и не представляет опасности.
У человека со сниженным иммунным статусом клебсиеллозная инфекция развивается в легких, кишечнике, мочеполовой системе, вследствие заражения от носителя бактерии или при употреблении инфицированных продуктов.
Определение патогена в моче проводится посредством бактериологического посева. Отклонением то нормы является показатель более 1000 КОЕ/мл.
Инфицирование беременной женщины угрожает ребенку патологиями внутриутробного развития. Клебсиелла в моче провоцирует развитие пиелонефрита, цистита, уретрита и других урологических заболеваний.
Терапия включает антибиотики, бактериофаги, витаминные комплексы.
Пути передачи инфекции
Наиболее распространенные пути передачи клебиеллы:
- воздушно-капельный (особенно интенсивный, когда больной человек кашляет или чихает);
- фекально-оральный (зараженный клебсиеллами кал попадает в грунт, оттуда – на овощи и фрукты, в питьевую воду).
Зафиксированы случаи, когда клебсиелла попадала в организм малыша при грудном вскармливании – при недостаточно тщательном уходе за сосками и в целом низкой гигиеной матери.
Носителем и передатчиком клебсиеллы всегда является человек.
Что такое TORCH-инфекции и чем они опасны для плода
Что такое клебсиеллезная пневмония: признаки и причины развития заболевания, пути заражения и методы диагностики, способы терапии

Анатомия слизистой оболочки человека включает в себя многообразную микрофлору. При исследовании материалов, взятых для анализа, легко выявить бактерию под названием «клебсиелла пневмония» (лат. Klebsiella pneumoniae).
Это условно патогенная палочка, которая находится преимущественно в органах дыхания, кишечнике, мочеполовых путях, также можно обнаружить на коже человека.
При нормальном соотношении с другими бактериями не наносит вреда организму, но при численном превосходстве становится возбудителем опасных заболеваний, в том числе и пневмонии. Была обнаружена в 1882 году микробиологом Карлом Фридлендером.
Причины развития
Клебсиелла пневмония в норме входит в микрофлору человека. Основные причины попадания палочки в организм:
- при рождении от матери к ребенку;
- на 5-7 сутки рождения в условиях стационара;
- во время приема пищи и употребления жидкости.
Долгое время эта бактерия сохраняет жизнеспособность, находясь на поверхностях предметов, растительных продуктах питания, в молоке.
Клебсиелла имеет небольшую округлую форму. Она неподвижна, так как не имеет жгутиков и не образует спор. Внешняя капсула хорошо защищает микроорганизм от воздействия окружающих факторов. Клебсиелла пневмония долгое время соседствует с человеком, не принося вреда. Но снижение иммунитета провоцирует развитие патогенной среды, что и приводит к серьезным заболеваниям.
Пути заражения
Основная масса инфекций передается через грязные руки и несоблюдение правил личной гигиены. Заболевания, вызванные клебсиеллой, не исключение.
Так как бактерия устойчива к внешним факторам и длительное время сохраняется на предметах и продуктах, ее риск попадания в организм через рот очень высок.
По этой причине, надо тщательно промывать овощи и фрукты, очищать рабочие поверхности, следить за чистотой рук.
Клебсиелла
Второй способ подхватить серьезную инфекцию – контакт с больным, если точнее, воздушно-капельным путем. Во время чихания, кашля выделяется огромное число бактерий клебсиелла пневмония. Попадая в организм здорового человека в большом количестве, патогенные микроорганизмы начинают активно развиваться. Инкубационный период длится в среднем неделю.
Дисбактериоз – третья причина обострения палочки Фридлендера, часто встречается среди заболевших. Длительное употребление антибиотиков значительно портит микрофлору кишечника и других слизистых. Численное превосходство условно-патогенных бактерий над полезными снижает местный иммунитет, инициируя заболевания желудочно-кишечного тракта и органов мочеполовой системы.
Клебсиелла пневмония вызывает серьезные инфекции у человека со сниженным иммунитетом. К группе риска относятся:
- новорожденные (особенно недоношенные) дети;
- пожилые люди;
- пациенты, перенесшие сложные операции.
Симптоматика
Первоначально Klebsiella pneumoniae классифицировалась, как тип микроорганизмов, вызывающих пневмонию. Бактерии данного вида локализуются на слизистых различных органов и систем, поэтому провоцируют разнообразные заболевания, непохожие друг на друга.
Легкие
Опасной по симптоматике и течению болезни считается клебсиеллезная пневмония. Очаги воспаления находятся в нижних отделах легких. Заболевание начинается как обычное ОРЗ. Воспаление развивается быстро и протекает в острой форме. Возникают следующие симптомы:
Высокая температура и слабость
- лихорадка и повышение температуры тела до высоких показателей;
- кашель и одышка;
- признаки интоксикации (головокружение, рвота, слабость);
- хрипы в легких;
- болевые ощущения в груди;
- мокрота с кровянистыми прожилками и неприятным запахом.
Когда бактерия поражает носоглотку, то симптомы следующие:
- насморк;
- воспаление в горле;
- атрофия слизистых;
- кашель с мокротой.
Если не начать своевременное и правильное лечение, появляется риск возникновения пневмонии.
Желудочно-кишечный тракт
Палочка Фридлендера способна вызвать следующие заболевания:
Гастрит
- гастрит;
- энтерит;
- энтероколит.
Симптоматика в каждом случае похожа. У больного появляются:
- рвота;
- жидкий стул;
- боли в области живота;
- слабость;
- сонливость;
- обезвоживание.
Диагностируется клебсиелла пневмония, в первую очередь, при анализе кала. В острой фазе заболевание продолжается не дольше 5 дней при наличии должного лечения.
Мочевыделительная система
Когда в моче пациента обнаруживают бактерию клебсиелла, это говорит о воспалительном процессе органов тазовой полости. Симптомы в этом случае могут быть такими:
Боли внизу живота
- боли внизу живота;
- рези при мочеиспускании;
- увеличение суточной нормы выделяемой жидкости;
- примеси крови в моче;
- повышение температуры тела;
- выделения из половых органов.
При воспалительном процессе, вызванном патогенным микроорганизмом, могут развиться осложнения:
- цистит;
- пиелонефрит;
- простатит.
Самое опасное – сепсис. Это состояние реальной угрозы для взрослого человека и, конечно, для ребенка.
Во время беременности женщинам стоит опасаться палочки Фридлендера. Особенность бактерии в том, что она легко проникает через плаценту и наносит серьезный урон внутриутробному развитию малыша. Если у роженицы началось воспаление на слизистой родовых путей, то после появления на свет грудничок может сразу заболеть пневмонией.
Клебсиеллезная пневмония выделяет вещества, способные привести к токсическому шоку. Своевременная и адекватная терапия останавливает развитие реакций патогенеза и помогает избежать осложнений.
Диагностика
Klebsiella pneumoniae вызывает серьезные патологические изменения в организме. Избежать последствий поможет правильная диагностика. К основным способам выявления бактерии относится лабораторный метод.
На анализ сдаются кал, моча, кровь. В зависимости от заболевания назначается мазок из горла, носа или цервикального канала.
Для подтверждения пневмонии и выявления точного нахождения очагов проводится рентген-исследование.
Самолечение при данном виде воспаления не допускается.
Методы терапии
Лечение заболеваний, вызванных клебсиеллой, осуществляется под строгим контролем врача и в стационарных условиях, так как воспаление быстро переходит в тяжелую форму. Терапия применяется таким образом, чтобы в кратчайшие сроки остановить распространение бактерии и снять появившиеся симптомы.
В клинике проведут необходимые анализы и назначат подходящие терапевтические мероприятия в зависимости от очага болезни и степени развития воспаления. Пациента лечат антибиотиками, к которым чувствительна Klebsiella pneumoniae, бактериофагами, пробиотиками, ферментами. По необходимости проводятся регидратационные мероприятия, чтобы избежать обезвоживания организма и застоя токсинов.
Кроме медикаментозного лечения, важно соблюдать постельный режим, пить много жидкости и регулярно проветривать помещение, где находится больной. Дополнительно могут быть назначены физиотерапия и народные средства (отвары и настои трав). Завершающим этапом станет месячный курс витаминосодержащих препаратов.
Профилактические меры
Предупредить попадание клебсиелла пневмонии в организм проще, чем лечить её. К основным профилактическим мероприятиям относятся:
- мытье рук несколько раз в день;
- соблюдение санитарных норм в больнице и домашних условиях;
- укрепление иммунитета;
- проветривание помещений;
- своевременное обращение к врачу при первых симптомах заболевания.
Простые привычки помогут избежать трудностей со здоровьем, вызванных палочкой клебсиеллой пневмония и другими патогенными микроорганизмами.
Klebsiella pneumoniae – что это такое, чем опасна бактерия и как от нее избавиться?
Бактериальные посевы позволяют выяснить состав микрофлоры на слизистых оболочках организма. Иногда результаты анализов показывают превышение допустимой концентрации некоторых микробов, что часто случается с Klebsiella pneumoniae. Прежде чем приобретать антибиотики и начинать лечение, важно изучить информацию об этом микроорганизме.
Klebsiella pneumoniae – что это?
Бактерия клебсиелла пневмония еще называется палочкой Фридлендера. Она представляет собой грамотрицательную факультативно-анаэробную коккобациллу. Микроб выглядит как продолговатая палочка с округлыми краями размером 0,6-0,8 на 1-2 мкм. Бактерия Klebsiella pneumoniae неподвижна, спор не образует, но может покрываться капсулой. Располагается одиночно, парно или скоплениями.
Рассматриваемый микроорганизм относится к условно-патогенной флоре. Это значит, что такая палочка в норме обитает на слизистых человека в небольшом количестве. Пока концентрация бактерий не превышает установленных границ, организм остается здоровым. Инфекционное заболевание начинается при бесконтрольном делении и распространении коккобацилл.
Клебсиелла пневмония – пути заражения
Представленный микроорганизм сохраняет жизнеспособность и вне человеческого тела, успешно переносит перепады температур внешней среды. Палочка Фридлендера в виде небольших групп может обитать даже на загрязненных продуктах питания, особенно мясных и молочных. Она передается такими способами:
- воздушно-капельный;
- контактно-бытовой;
- фекально-оральный;
- половой.
Чем опасна Klebsiella pneumoniae?
Увидев в результатах бактериального посева описываемый микроорганизм, не стоит пугаться и начинать прием антибиотиков. Следует вспомнить характеристики Klebsiella pneumoniae, что это такое и какие имеет особенности.
Условно-патогенные палочки не несут угрозы, пока их количество остается в пределах установленных норм.
Это стандартная составляющая здоровой микрофлоры организма, она может присутствовать в кишечнике, ротовой полости и влагалище, на поверхности кожи.
Инфекционное поражение возникает, когда концентрация бактерий выше определенных границ. Такие случаи характерны для периодов ослабления иммунной системы, что приводит либо к инфицированию заразными формами палочки Фридлендера, либо к патологическому размножению собственных коккобацилл.
Чем опасна клебсиелла пневмония:
- урогенитальные заболевания;
- фиброзные и гнойные плевриты;
- острые гастриты;
- абсцессы селезенки и печени;
- гаймориты;
- воспаление легких;
- эндофтальмиты;
- перикардиты;
- гастродуодениты.
Чтобы выявить указанный микроорганизм, используется три варианта анализов:
- бактериоскопия;
- серологическое исследование;
- бактериальный посев.
Они помогают определить наличие и количество палочек Фридлендера в биологических жидкостях, кале, слизи и массах, выделяемых гнойными очагами. Анализ Klebsiella pneumoniae проводится для:
- мочи;
- мокроты из легких и бронхов, в ротовой полости;
- слизи цервикального канала;
- кала.
Klebsiella pneumoniae – норма
Зная, что представленная коккобацилла присутствует и в абсолютно здоровом организме, необходимо сравнивать полученные результаты исследований с установленными пределами концентрации бактерий.
Не во всех анализах может наблюдаться клебсиелла пневмония, норма для некоторых биологических материалов – ноль.
Расшифровывать лабораторные исследования самостоятельно сложно, поэтому с результатами лучше сразу отправиться к лечащему доктору.
Клебсиелла пневмония в моче
В этой биологической жидкости рассматриваемый микроорганизм не должен присутствовать. Klebsiella pneumoniae в моче считается патологией, что свидетельствует об инфицировании слизистых оболочек выводящей системы.
Заразиться можно половым и контактно-бытовым путем, особенно при несоблюдении правил личной гигиены, использовании чужих полотенец и белья.
Существуют разные инфекции, для которых характерно наличие в моче Klebsiella pneumoniae, что это такое в контексте заболеваний:
- кольпит;
- цистит;
- пиелонефрит;
- уретрит;
- гломерулонефрит.
Клебсиелла пневмония в кале
Фекальные массы исследуются для получения или уточнения информации о состоянии микрофлоры слизистых оболочек кишечника и его функционировании. Klebsiella pneumoniae в кале – нормальное явление. В ограниченных количествах она присутствует в системе пищеварения и поддерживает индивидуальный биоценоз, обеспечивая правильную работу иммунитета.
Нормой для описываемой палочки считается концентрация 105 на 1 г биологического материала. Многие современные гастроэнтерологи подчеркивают необходимость трактовки анализа в соответствии с общим самочувствием, особенностями питания и образа жизни.
Важно понимать суть количества Klebsiella pneumoniae, что это такое же индивидуальное свойство организма, как цвет глаз или тембр голоса.
У каждого человека неповторимая личная микрофлора кишечника, и превышение указанной нормы не всегда свидетельствует о патологии.
Причины говорить о патологии появляются, когда слишком большое количество микробов сочетается со специфическими симптомами. Это сигнализирует об инфекции, что развивается в просвете одного из отделов кишечника. Могут прогрессировать такие заболевания:
Клебсиелла в моче

Полезные и вредные бактерии мирно уживаются в микробиоте кишечника только при условии их четкого количественного соотношения. Условно-патогенная бактерия клебсиелла является частью микрофлоры кишечника и не доставляет проблем, пока здоровая иммунная система контролирует размножение болезнетворных микроорганизмов.
При ослабленном иммунитете любое негативное экзокринное (внешнее) воздействие стимулирует активность патогенов и развитие инфекционных процессов в организме. Присутствие анормального количества клебсиеллы в моче является клиническим признаком инфицирования мочевыделительной системы или обширного сепсиса.
Общие сведения
Klebsiella – это представитель семейства энтеробактерий (грамотрицательных), обитающих в кишечнике. Относится к нестрогим (факультативным) аэробам – микроорганизмам, способным расти и размножаться как в бескислородной среде, так и при доступе кислорода. Бактерия имеет палочкообразную форму, широко распространена в растительном мире и в почве.
Обладает адаптивной способностью к высоким температурам (до 60 градусов) и холоду. Сохраняет жизнеспособность в продуктах питания (даже при хранении в холодильнике). При активизации патоген становится токсичным, особенно в отношении слизистой ЖКТ (желудочно-кишечного тракта) и легких.
Важно! Клебсиелла обладает резистентностью (устойчивостью) ко многим видам антибиотиков и антисептиков. Эффективная терапия может быть назначена только по результатам дифференцированной лабораторной диагностики.
Основные виды условно-патогенного микроорганизма:
- Klebsiella oxytoca (клебсиелла окситока). Активизируется на поверхности кожи, на слизистой оболочке толстой кишки, в ротовой и носовой полости. Превышение нормы в анализах мочи определяется редко.
- Klebsiella pneumоniae (клебсиелла пневмония, иначе – палочка Фридлендера). Основной областью локации выбирает легкие, вызывая тяжелые формы пневмонии, особенно у детей. Может колонизировать в органах мочевыделительной системы, пищеварительного тракта и носоглотки. При обнаружении в моче ненормированного количества бактерий диагностируются воспалительные заболевания мочеполовой системы.
- Klebsiella planticola (клебсиелла плантикола). Лабораторная дифференциация мочи на выявление данного вида проводится в случае обнаружения плантиколы в мазках из зева или в прямой кишке у ребенка до трехмесячного возраста.
- К редким видам клебсиеллы относятся палочка Волковича-Фриша и палочка Абеля.
Причины активизации клебсиеллы
В период своего активного размножения микроорганизм отличается высокой вирулентностью (способностью заражать организм), контагиозностью (передачей при контакте с больным человеком). Бактерии клебсиеллы у взрослых и детей активизируются под влиянием корреляции двух факторов: низкий уровень иммунитета и контакт с источником заражения. Пути передачи инфекции:
Бактерии в моче у мужчин
- Воздушно-капельный. Посредством вдыхания зараженного воздуха при близком общении с инфицированным пациентом.
- Алиментарный. Через зараженные продукты, при несоблюдении личной гигиены и гигиены питания.
У здорового человека защитные силы противостоят активации не только собственных патогенов, но тормозят развитие клебсиеллы при контакте с инфекцией. Ослабленная иммунная система утрачивает способность сопротивляться, что приводит к увеличению численности бактериальной колонии. Причины ослабления иммунитета могут быть следующие:
- хронические заболевания мочеполовой и дыхательной системы;
- эндокринные патологии (сахарный диабет, болезни щитовидной железы и т.д.);
- ВИЧ и СПИД;
- дефицит витаминов и минералов (нездоровое питание);
- усиленная реакция иммунной системы по выработке антител (частые аллергии);
- некорректная терапия антибактериальными препаратами;
- наличие злокачественных и доброкачественных новообразований;
- хронический алкоголизм;
- эпидемический период гриппа.
Нередко бактерии обнаруживаются в анализах мочи у пожилых людей, что связано с возрастным снижением иммунного статуса.
Клебсиелла у беременных и младенцев
Отдельного внимания заслуживает распространение патогенной бактерии в организме беременных женщин. В перинатальный период активизируется половой гормон прогестерон, основной задачей которого является сохранение плода. Для предотвращения отторжения эмбриона (выкидыша), прогестерон начинает подавлять иммунитет.
Ослабленный организм поддается инфицированию. Особенно опасно распространение бактерий в органах малого таза в третьем триместре. Активность патогенов может прервать беременность либо спровоцировать преждевременное родоразрешение.
Патоген обладает способностью преодолевать плацентарный барьер. Обнаруженная в моче беременной женщины бактерия указывает на развитие внутриутробных инфекций, связанных с поражением дыхательной системы и мочевыводящих путей. При несвоевременном лечении патология будет диагностирована у новорожденного ребенка.
Согласно медицинской статистике, выявление Klebsiella составляет 42,8% от всех случаев заболеваний мочеполовой системы у младенцев
Наличие патологических процессов беременная женщина может заподозрить по следующим симптомам:
- тяжесть в эпигастральной области;
- болезненные ощущения в грудной клетке;
- боли при опорожнении мочевого пузыря;
- слабость;
- тошнота и рвотные позывы.
Важно! Клебсиеллозная инфекция может стать причиной анормального развития ребенка и преждевременных родов.
Клебсиелла относится к нозокомиальным (внутрибольничным) инфекциям. В силу несовершенства иммунной системы маленькие дети легко заражаются во время пребывания в стационаре.
Активность патогена в младенческом возрасте проявляется признаками острого дисбактериоза.
У новорожденного наблюдается фебрильная температура тела (38–39°С), капризность и гипоактивность (вялость), кашель, расстройство стула (понос), рвота (срыгивание), вздутие живота.
Усиление симптомов приводит к дегидрации (обезвоживанию) организма.
Для дифференциации инфекции назначается анализ крови, специальный анализ на дисбактериоз, копрограмма (расширенное исследование кала), бактериологический посев кала на определение патогенного микроорганизма и подбор соответствующего антибиотика. При обнаружении в каловых массах у грудничка Klebsiella pneumoniae (в концентрации 10 в 5 степени и выше) назначается лечение инфекционного заболевания.
Сопутствующие заболевания
При проникновении бактерий в урину (мочу) прогрессируют болезни мочеполовой системы:
- воспаление мочеиспускательного канала (уретрит);
- воспаление слизистой влагалища у женщин (кольпит);
- воспалительное поражение стенок мочевого пузыря (цистит);
- воспалительный процесс в канальцевой системе почечного аппарата (пиелонефрит).
Болезнетворный микроорганизм является опасным не только для мочевыделительных органов. Обладая высокой токсичностью, Klebsiella может вызывать интоксикацию всего организма и развитие септических процессов.
Сепсис – тяжелая вторичная инфекция, развивающаяся как ответ на бактериальную инфекцию.
Характеризуется распространением гнойно-воспалительного процесса по кровотоку из источника инфекции ко всем органам (заражение крови).
Диагностика, нормы содержания Klebsiella и отклонения
Поставить диагноз клебсиеллозной инфекции можно только на основе лабораторной микроскопии. Пациенту с подозрением на заражение назначается общий анализ крови, анализ мочи общий, бактериоскопия мазка со слизистых, бакпосев мочи. В качестве вспомогательного исследования применяется серологический метод выявления антигенов или антител в крови.
Бакпосев, или бактериологический посев, является высокоточным методом лабораторной диагностики по определению возбудителя заболеваний и его реакции на антибактериальную терапию. Бактериологический посев выполняется в лабораторной емкости (чашке Петри), которая заполняется специальной средой, благоприятной для размножения микроорганизмов.
Туда же помещается проба мочи. Если патогены присутствуют, они начинают активно увеличивать свою численность. На выращенной колонии бактерий проводится оценка их резистентности на разные виды антибиотиков.
Оценка концентрации бактерий в моче
Оценка анализа производится посредством сравнения референсных (усредненных) значений численности КОЕ с полученными результатами исследования.
Количество КОЕ (колониеобразующие единицы) подсчитывается в одном мл жидкости и является биовеличиной в микробиологии. Поскольку Klebsiella является обитателем кишечной флоры, в идеале в моче ее быть не должно.
Однако незначительная бактериурия допускается и не считается патологией.
Клебсиелла пневмония в моче определяется так же, как другие энтеробактерии:
- менее 1000 КОЕ/мл – не является отклонением, и не требует специфического лечения;
- превышение показателя 1000 КОЕ/мл (10 в 3 степени) – указывает на воспаление в мочеточниках, уретре, мочевом пузыре.
Антибиотикограмма (определение на резистентность к антибиотикам) проводится при результатах более 10000 КОЕ/мл. В некоторых лабораториях принята следующая норма условно-патогенных бактерий (энтеробактер, графния, цитробактер и др.), к которым относится клебсиелла. Результат 100 000 КОЕ/мл (10 в 6 степени) и более – признак острого воспалительного процесса в органах мочеполовой системы.
Дифференциация клебсиеллы окситока при бакпосеве производится редко, по специальному назначению. Данная разновидность клебсиеллозной бактерии активизируется в основном в желудочно-кишечном тракте, вызывая гастрит, энтероколит, энтерит и т.д.
Правила сбора мочи для бактериологического посева
Точность показателей КОЕ в анализах обеспечивает соблюдение следующих условий подготовки:
- собрать урину необходимо в утреннее время в стерильный контейнер, заранее приобретенный в аптеке;
- перед сбором мочи следует провести гигиену половых органов без мыла;
- для анализа нужна средняя порция мочи, т.е. помочиться нужно сначала в унитаз, далее в контейнер, затем снова в унитаз.
Женщинам во время мочеиспускания рекомендуется прикрыть ватным спонджиком или тампоном влагалище. Перед анализом нельзя пользоваться вагинальными контрацептивами.
Симптомы и лечение
При активизации Klebsiella pneumоniae в органах мочевыделительной системы проявляются симптомы тех заболеваний, которые бактерия провоцирует: поллакиурия (частое мочеиспускание), сопровождаемое болезненными ощущениями жжения, наличие кровяных вкраплений в урине, тянущие или режущие боли внизу живота, гипертермия.
Лечение инфекции проводится с применением нескольких групп медикаментов:
- Антибиотики. Терапия подбирается индивидуально, с учетом результатов антибиотикограммы.
- Бактериофаг Клебсиелл Пневмонии. Антибактериальный препарат специфического действия.
- Пробиотики. Лекарства на основе полезных микроорганизмов здоровой кишечной флоры.
- Витаминно-минеральные комплексы для укрепления иммунитета.
В качестве вспомогательной терапии используют народные средства в виде общеукрепляющих отваров. Дети до 14 лет проходят лечение в условиях стационара. Во время беременности применение антибиотиков допустимо только со второй половины перинатального периода и при условии, что угроза жизни матери превышает тератогенное воздействие на плод.